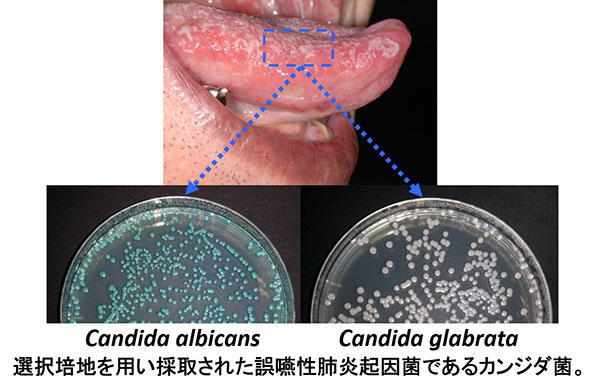
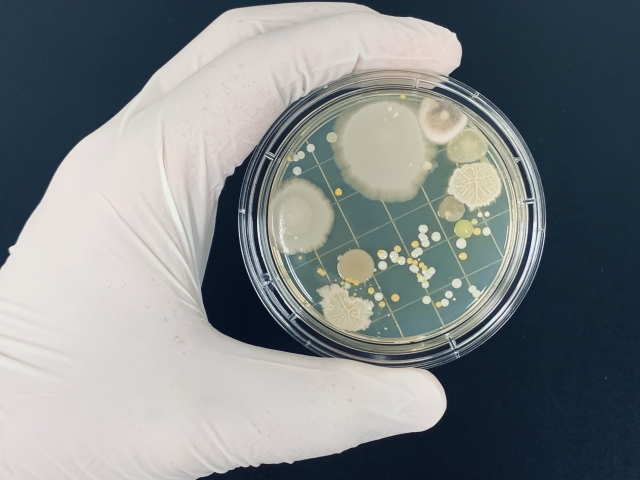

カンジタ 画像 (384 無料写真)
再発注意!膣カンジダ症の治療と予防について産婦人科の専門医が徹底解説。
皮膚真菌症 カンジダ、癜風、マラセチア 虎ノ門中村クリニック 神谷町院。
食道カンジダ症の症例写真と解説夙川内視鏡内科まえだクリニック 西宮市で痛くない胃カメラ・下剤を飲まない大腸カメラを土曜日曜も実施。
甘いものやめられない 」のはカンジタ菌のせいかも!杉並区 鍼灸師&テルミー療術師が伝える 安産・産後・子育てを元気にすごすための秘訣。
表在性カンジダ症 Superficial candidiasis– 感染症 - 神戸きしだクリニック 神戸市中央区。
甘いものやめられない 」のはカンジタ菌のせいかも!杉並区 鍼灸師&テルミー療術師が伝える 安産・産後・子育てを元気にすごすための秘訣。
抗生物質服用後の皮膚カンジタ症の鍼灸治療の症例名古屋市中川区高畑の蓬祥鍼灸院。
カンジダ用市販薬のおすすめ人気ランキング 陰部のかゆみに効く?2025年10月マイベスト。
感染症検査 4点セット 男性用クラミジア、淋菌、トリコモナス、カンジタ健康管理館Webshop -郵送検査キットの販売-。
カンジダは自然治癒するのか? 原因・症状・薬 天神マイケアクリニック。
表在性カンジダ症 Superficial candidiasis– 感染症 - 神戸きしだクリニック 神戸市中央区。
◇ 膣カンジタ症 _____mominotemomi疾患ノートmomi領域別看護膣カンジダカンジダ母性看護学看護学生勉強垢 看護学生応援 勉強応援infy勉強垢勉強勉強垢さんと一緒に頑張りたい看護師勉強垢レビューブック 付箋ノート ふせんノート看護師。
口腔カンジダの写真やイラストはどのようなものですか? 口腔カンジダ。
指の間全部にカンジタができ来店~改善までを掲載中!│アトピー性皮膚炎相談専門 くすりのファイン。
男性の性器カンジダ症 原因と症状、検査・治療法 • メンズケアクリニック新橋院。
カンジダは自然治癒するのか? 原因・症状・薬 天神マイケアクリニック。
カンジダ症 腟カンジダ はうつる?原因と症状、治療法 公式 新宿駅前婦人科クリニック。
皮膚カンジダ症の写真 - 医療のイラスト・写真・動画、素材販売サイトのメディック medick。
カンジダ症 - 17. 皮膚の病気 - MSDマニュアル家庭版。
カンジダは自然治癒するのか? 原因・症状・薬 天神マイケアクリニック。
なぜカンジダはこんなに手ごわいのか?腸カンジダがしぶとい理由と対策 - 京橋ウェルネスクリニック。
高齢者によくみられる皮膚の悩み:「白癬 水虫 」と「カンジダ症」。
AmazonカンジダディテクターDC-140 10イリ ヨウレイゾウ カンジタディテクター デントケア24-8042-001本単位松吉医科器械口腔ケア介助用品。
食道カンジダ症の症例写真と解説夙川内視鏡内科まえだクリニック 西宮市で痛くない胃カメラ・下剤を飲まない大腸カメラを土曜日曜も実施。
カンジタ症状か痒みが強い 婦人科症状 イラスト - No: 25918792無料イラスト・フリー素材なら「イラストAC」。
お口の中にカビの原因菌?「カンジタ菌」にご注意! 訪問歯科事務局ブログ大阪・兵庫で訪問歯科なら健志会グループ。
泌尿器科専門医 ドクター尾上の医療ブログ:カンジダ。
皮膚カンジタ症の鍼灸治療の症例名古屋市中川区高畑の蓬祥鍼灸院。
楽天市場第1類医薬品 フェミニーナ膣カンジダ錠 1箱 6錠フェミニーナ 腟カンジダ 再発 治療薬 婦人薬 カンジタ症 カンジダ膣錠 :タカラ薬局楽天市場店。
腟カンジダ カンジダ症 ってどんな症状?メディトリート。
男性の性器カンジダ症 原因と症状、検査・治療法 • メンズケアクリニック新橋院。
カンジタ症10年間悩まされていた カンジタ症が良くなられた方の体験談をご紹介! ▹▸30代 女性 お知り合いが17年間お子さんができず悩んでいたけどここのNS乳酸菌で 子どもさんができたことから ご自身も飲んでみたいということで ご相談に来られたのが最初の出会い。
抗生物質服用後の皮膚カンジタ症の鍼灸治療の症例名古屋市中川区高畑の蓬祥鍼灸院。
カンジタの検査・治療医療法人男健会 三条河原町診療所京都。
女性用 カンジダ検査カンジタ郵送検査のお申込み 自宅で出来る性病検査 STD検査 安心と信頼のさくら検査研究所。
膣カンジタになりやすい人はパン食、砂糖を控えてみる - 不妊、妊活、更年期相談の島田薬局石川県,金沢市の不妊症に漢方薬,カウンセリングでサポートします。
女性の膣カンジタには要注意!白髪の改善や予防防止・育毛・発毛のラ・フィーネラボ。
腸管カンジダ症」原因は腸内“真菌”の異常な増殖!検査や治療、セルフケアの方法 - 国立消化器・内視鏡クリニック。
子供の皮膚疾患おむつかぶれとカンジタ皮膚炎 - 有明みんなクリニック・有明こどもクリニック総合サイト。
リポスト - @saachan.sensei by @get_multi_repost .白癬菌の爪 に是非使って!菌バスター 🦠もちろん! 白癬菌だけじゃなく 緑膿菌、カンジタ菌、その他もろもろの菌 撃退! なのにお肌には優しい成分♪緑膿菌緑膿菌予防白癬菌白癬菌対策カンジダ菌爪の。
カンジタ カンジダ についての情報症状、原因、治療法について港区の麻布十番たちばな泌尿器科・皮膚科クリニック。
なぜカンジダはこんなに手ごわいのか?腸カンジダがしぶとい理由と対策 - 京橋ウェルネスクリニック。
男性の性器カンジダ症 原因と症状、検査・治療法 • メンズケアクリニック新橋院。
カンジダは自然治癒するのか? 原因・症状・薬 天神マイケアクリニック。
表在性カンジダ症 Superficial candidiasis– 感染症 - 神戸きしだクリニック 神戸市中央区。
デリケートゾーンのかゆみ・膣カンジタ等 皮膚薬イオンスタイルオンライン 衣料品・暮らしの品をネットでお買物。